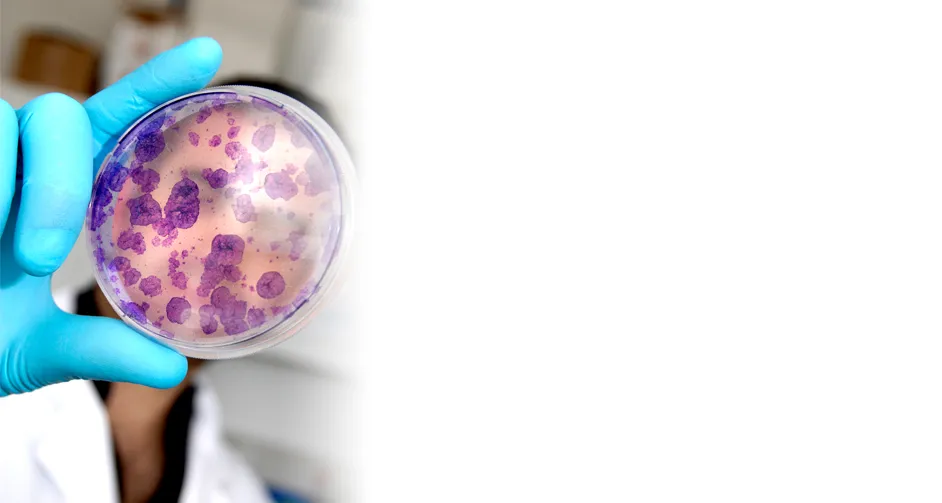
Guérir - Biothérapies et maladies fréquentes - AFM-Téléthon

Biothérapies et maladies fréquentes
Des innovations qui concernent la médecine toute entière
Les biothérapies produisent des connaissances, des outils et des innovations thérapeutiques déterminantes pour traiter les maladies fréquentes.Il existe de nombreuses passerelles entre la recherche sur des maladies parfois très rares et des maladies qui sont très fréquentes. Aussi, les biothérapies à l’essai aujourd’hui pour les maladies rares, vont concerner demain beaucoup d’autres affections. Fidèle à sa stratégie d’intérêt général, l'AFM-Téléthon encourage l'émergence de thérapies innovantes qui ouvrent des perspectives à la médecine dans son ensemble.
Lire : Comprendre les biothérapies : thérapie génique, thérapie cellulaire, pharmacogénétique...
- La progéria, maladie ultra-rare, caractérisée par un vieillissement accéléré, partage des mécanismes communs avec le vieillissement physiologique (progressif) et le vieillissement accéléré induit par les chimiothérapies anticancéreuses ou trithérapies anti-sida. Les options thérapeutiques de la progéria ouvrent donc des perspectives pour des affections qui concernent l’ensemble de la population.
- Le déficit dans la chaîne respiratoire mitochondriale observé dans la neuropathie optique héréditaire de Leber (NOHL), maladie rare de la vision, est commun à la plupart des maladies fréquentes (maladie de Parkinson, le vieillissement, le cancer). La capacité de délivrer un gène thérapeutique dans la mitochondrie – l’organe énergétique de toutes les cellules, grâce aux outils de thérapie génique mis au point pour la NOHL, ouvre la voie au traitement des déficits mitochondriaux observés très largement dans les pathologies fréquentes.
- La β-thalassémie, maladie génétique rare affectant les globules rouges, est dûe au même gène que la drépanocytose qui concerne une large proportion de la population africaine, noire-américaine, méditerranéenne et asiatique. La thérapie génique mise au point pour la β-thalassémie sera étendue à la drépanocytose.
- Les thérapies cellulaires régénératrices expérimentées pour le traitement de cardiopathies observées dans de nombreuses myopathies ont très vite vu leurs applications étendues à l’insuffisance cardiaque consécutive à l’infarctus.
- La thérapie cellulaire de la peau envisagée pour certaines maladies génétiques cutanées ou pour des complications cutanées de maladies génétiques est applicable au traitement des grands brûlés ainsi qu’aux ulcérations cutanées chroniques complications liées au diabète de type II et aux déficiences veineuses graves.
Enfin, l’évolution vers une médecine adaptée spécifiquement à chaque patient, prenant en compte son patrimoine génétique, métabolique et environnemental («le bon traitement, au bon patient, au bon moment »), s’appuiera précisément sur le modèle développé pour les maladies rares.